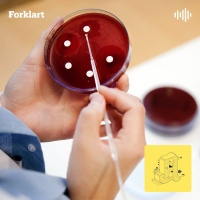
Hva skjer om antibiotika slutter å virke?

Sinopsis
Hos oss i Aftenposten jobber mange av landets dyktigste journalister. Vi lager haugevis med nyheter hver dag. Noen saker gir helt ny innsikt, andre setter dagsorden, feller statsråder eller endrer lover. Men mange viktige historier drukner også i støyen. Er du som oss, har du litt for ofte en følelse av at du ikke rekker å få med deg mer enn overskriftene. Derfor har vi laget den daglige nyhetspodkasten Forklart. Hver dag ser vi nærmere på en interessant nyhetssak, og spør: Hvor starter historien? Hvorfor skjer dette nå? Og hva betyr det egentlig?Sammen med Aftenpostens journalister, kommentatorer og utenrikskorrespondenter, gir programleder Andreas Bakke Foss deg innsikten du trenger for å forstå nyhetene litt bedre.Forklart er en podkast fra Aftenposten. Den er laget av Karoline Fossland, Anders Veberg og Andreas Bakke Foss. Aftenposten arbeider etter Vær Varsom-plakatens regler for god presseskikk.Nyhetsredaktør: Tone Tveøy Strøm-GundersenSjefredaktør: Espen Egil HansenHar du spørsmål eller tilbakemeldinger kan du kontakte oss på forklart@aftenposten.no eller på Facebook-siden Forklart.
Episodios
-
Vil du ligge? Svar ja eller nei.
25/04/2024 Duración: 16minHelsemyndighetene har lansert en ny veiviser rettet mot unge om ligging. Selv om dette er gjort med glimt i øyet, er bakgrunnen alvorlig. 1 av 5 kvinner sier de har blitt voldtatt. Mange krever en samtykkelov, men er det løsningen? Journalistene Anine Hallgren og Tonje Egedius forklarer. Foto: Aftenposten / Rodrigo Freitas
-
Historisk støttepakke: Blir den et vendepunkt for Ukraina?
24/04/2024 Duración: 15minUSAs nye støttepakke til Ukraina har latt vente på seg, men nå kommer den. Kan den endre krigen i Ukraina? Med utenriksjournalist Per Anders Johansen. Foto: Andrew Harnik/AP
-
Russiske spioner: Slik jobber de
23/04/2024 Duración: 16minRussiske spioner vil utgjøre en av de største etterretningstruslene i Norge fremover. Hvordan jobber de? Og hvorfor lar noen seg rekruttere og gå med på å dele hemmelige opplysninger med en annen stat? Med journalist Hanne Marie Maugesten. Foto: Aftenposten/Monica Strømdahl
-
Midtøsten: Hvem er på lag med hvem?
22/04/2024 Duración: 15minMidtøsten preges av flere forskjellige allianser. Det mange har til felles er at de enten er for eller mot Iran. Men hvem er hvem, og hva vil de egentlig? Med nylig avgått Midtøsten-korrespondent Hanne Christiansen. Foto: hyotographics/Shutterstock
-
Revolusjon i Rød Ungdom? Derfor ble det bråk
19/04/2024 Duración: 15minRødts ungdomsparti, Rød Ungdom, fikk en dramatisk helg da en ny ledelse overtok. Noen kaller det et kupp. Bør ungdomspartiet deles i to? Med politisk journalist Henrik Giæver og kommentator Andreas Slettholm. Foto: Lise Åserud / NTB
-
Kan Baneheia-saken bli oppklart nå?
18/04/2024 Duración: 13minI år 2000 ble to jenter funnet misbrukt og drept i Baneheia, men saken som rystet Norge er fortsatt ikke løst. Nye DNA-bevis har ført Jan Helge Andersen tilbake på tiltalebenken. Journalist Andreas Bakke Foss forklarer. Foto: Ane Hem / NTB.
-
EØS fyller 30 år! Hurra?
17/04/2024 Duración: 16minEt utvalg har sett på hvilke alternativer vi har til EØS-avtalen. Hvor god er egentlig avtalen? Og er avtalen bedre enn et fullverdig EU-medlemskap? Politisk redaktør Kjetil B. Alstadheim forklarer. Foto: Melinda Nagy/Shutterstock.
-
Bergen: Derfor ble de frifunnet
16/04/2024 Duración: 11minFrifinnelsene i det som er blitt omtalt som «gruppevoldtektssaken i Bergen», har opprørt mange. Hvordan kunne to menn først bli dømt, og så frifunnet? BT-journalist Hanad Ali forklarer. Foto: Politiet
-
Blir det storkrig nå? Alt handler om hvordan Israel svarer
15/04/2024 Duración: 15minNatt til søndag ble flere hundre droner og missiler skutt fra iransk jord mot israelsk territorium. Blir det storkrig nå? Og hvorfor gjør Iran dette? Med tidligere Midtøsten-korrespondent Hanne Christiansen. Foto: Ronen Zvulun, Reuters/NTB
-
Anbefaling: Spionen i Drammensveien
14/04/2024 Duración: 34minHør den nye dokumentarserien til Aftenposten. I Spionen i Drammensveien forteller vi historien om en russisk spion som kom til Norge, vi har snakket med mannen han forsøkte å rekruttere og de som forsøkte å stoppe ham. Resten av serien hører du i Aftenposten-appen eller hos Podme.
-
Derfor fikk helseministeren sparken
12/04/2024 Duración: 07minJonas Gahr Støre har konkludert med at Ingvild Kjerkol ikke kan være helseminister. – Jeg er oppriktig lei meg, sier statsministeren om avgjørelsen. Hvorfor måtte Kjerkol gå? Med politisk journalist Odd Inge Aas. Foto: Cornelius Poppe / NTB
-
Hva skjer om antibiotika slutter å virke?
12/04/2024 Duración: 15minAntibiotikaresistente bakterier sprer og formerer seg raskere enn noen gang før. Gonoré gir oss en forsmak på hvilke utfordringer dette kan bringe med seg i fremtiden. Med journalistene Fride Næss Nonstad og Bjørn Egil Halvorsen. FOTO: Fartein Rudjord/Aftenposten.
-
Press og stress: De unge som faller utenfor
11/04/2024 Duración: 13minTusenvis av unge står utenfor jobb og utdanning i Europa. Mange har psykiske lidelser. Arbeidsminister Tonje Brenna kaller det dramatisk og varsler tiltak for å stanse utviklingen i Norge. Europa-korrespondent Rakel Haugen Strand forklarer. Foto: Gorm Kallestad / NTB
-
Hvordan skal Forsvaret bruke 600 milliarder?
10/04/2024 Duración: 14minEtter mange år med fredelige forhold, må det norske Forsvaret nå rustes opp. Det skal brukes mye penger, og mange flere skal ansettes. Hva skal pengenes brukes på? Og hva må i så fall prioriteres ned? Med politisk redaktør Kjetil B. Alstadheim. Foto: Stian Lysberg Solum/NTB
-
Vil styre USA med bibelen: Nei til abort og spiral
09/04/2024 Duración: 16minI Alabama har nå et befruktet egg de samme rettighetene som en vanlig person. Flere kristen-konservative krefter vil nå at dette skal gjelde for hele USA. Hvem trekker i trådene? Og hvordan får de makt? Med kommentator Christina Pletten. Foto: Nora Savosnick
-
Vi får færre barn. Gjør det egentlig noe?
08/04/2024 Duración: 15minDet er ikke bare i Norge at fødselstallene går ned. Det samme skjer over hele verden. Hva betyr det at vi blir færre? Kommentator Andreas Slettholm forklarer.
-
Hvorfor angrep Israel hjelpearbeidere på Gaza?
05/04/2024 Duración: 13minMandag ble syv hjelpearbeidere drept i et israelsk angrep. Israel kaller det en feil. Men nye detaljer avslører at noe ikke er som det skal i det israelske militæret. Journalist Hanne Christiansen forklarer. Foto: Ahmed Zakot, Reuters/NTB
-
Svak krone kan heve renten. Men det finnes løsninger.
04/04/2024 Duración: 16minDen norske kronen sliter, og det har den gjort en stund nå. Kan det fikses? Og i så fall hvordan? Med E24-kommentator Sindre Heyerdahl.
-
Temu er superbillig. Men bør du handle der?
03/04/2024 Duración: 16minNettbutikken Temu frister oss med alle mulige varer til latterlig lave priser. Hvordan er det mulig? Journalist Kristoffer Rønneberg forklarer. Foto: NTB / Scanpix
-
Skulle vi ikke slutte med sommertid?
02/04/2024 Duración: 13minFlere og flere land dropper sommertid og nå kan Norge følge etter. Hva er grunnen til at vi stiller klokken to ganger i året? Med produsent og journalist Olav Eggesvik. Kilder vi har brukt i episoden: Almanakken (https://www.mn.uio.no/astro/tjenester/publikum/almanakken/innhold/tema2004.html), Regjeringen (https://www.regjeringen.no/no/sub/eos-notatbasen/notatene/2018/sep/direktiv-om-avskaffelse-av-arstidsbestemt-tidsomstilling-og-om-oppheving-av-direktiv-200084ec/id2620427/), Stortinget (https://www.stortinget.no/no/Saker-og-publikasjoner/Sporsmal/Skriftlige-sporsmal-og-svar/Skriftlig-sporsmal/?qid=93756), BBC (https://www.bbc.com/future/article/20240308-how-first-suggestions-of-daylight-savings-time-was-inspired-by-insects), Franklin Institute (https://fi.edu/en/science-and-education/benjamin-franklin/daylight-savings-time), EU (https://www.consilium.europa.eu/en/policies/seasonal-time-changes/timeline-seasonal-clock-changes-in-the-eu/)